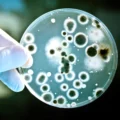

OECD Sağlık Verileri: Türkiye’deki hemşirelerin %76’sı yurt dışında çalışmak istiyor
Ekonomik Kalkınma ve İşbirliği Örgütü (OECD) Sağlık Verileri 2022’ye göre, Türkiye 100 bin nüfusa düşen toplam hemşire sayısında 43 ülke...
DevamıHüseyin Kandemir wrote a new post, Toplum Temelli Onkoloji ve Evde Bakım, Meme ve Akciğer Kanserinde Sağkalımı İki Kat Arttırıyor! 3 gün 21 saat önce
 Toplum Temelli Onkoloji ve Evde Bakım, Meme ve Akciğer Kanserinde Sağkalımı İki Kat Arttırıyor!ABD’de 220’den fazla toplum temelli onkoloji merkezinden elde edilen gerçek yaşam verilerine dayanan yeni bir analiz, bu merkezlerde ve evde yapılan kanser tedavisinin, meme ve akciğer kanseri hastalarında sağkalımı nerdeyse iki kat arttırdığını gösteriyor.
Toplum Temelli Onkoloji ve Evde Bakım, Meme ve Akciğer Kanserinde Sağkalımı İki Kat Arttırıyor!ABD’de 220’den fazla toplum temelli onkoloji merkezinden elde edilen gerçek yaşam verilerine dayanan yeni bir analiz, bu merkezlerde ve evde yapılan kanser tedavisinin, meme ve akciğer kanseri hastalarında sağkalımı nerdeyse iki kat arttırdığını gösteriyor.
Hüseyin Kandemir wrote a new post, Yeni Geliştirilen Yöntem Kanser Hücrelerini Bağışıklık Sistemi İçin Görünür Hale Getirerek Yok Ediyor 2 hafta önce
 Yeni Geliştirilen Yöntem Kanser Hücrelerini Bağışıklık Sistemi İçin Görünür Hale Getirerek Yok EdiyorYeni yapılan bir çalışma, kanser hücrelerini bağışıklık sistemi için daha görünür hale getirerek immünoterapinin tümör hücrelerine karşı etkisini önemli oranda arttırıyor. Yaklaşık 1.000 hasta verisi ile yapılan yeni araştırma, tümör antijenlerini açığa çıkararak T hücrelerinin tümör dokusunu fark etmesini sağlayabileceğini gösterdi.
Yeni Geliştirilen Yöntem Kanser Hücrelerini Bağışıklık Sistemi İçin Görünür Hale Getirerek Yok EdiyorYeni yapılan bir çalışma, kanser hücrelerini bağışıklık sistemi için daha görünür hale getirerek immünoterapinin tümör hücrelerine karşı etkisini önemli oranda arttırıyor. Yaklaşık 1.000 hasta verisi ile yapılan yeni araştırma, tümör antijenlerini açığa çıkararak T hücrelerinin tümör dokusunu fark etmesini sağlayabileceğini gösterdi.
Hüseyin Kandemir wrote a new post, Evlilik Kanserden Koruyor! 4 Milyon Hasta Verisi: Bekarlarda Kanser Riski 3 Kat Daha Fazla 3 hafta 4 gün önce
 Evlilik Kanserden Koruyor! 4 Milyon Hasta Verisi: Bekarlarda Kanser Riski 3 Kat Daha FazlaABD’de 4 milyondan fazla kanser vakasını inceleyen bilim insanları hiç evlenmemiş yetişkinlerde kanser riskinin evli veya boşanmış kişilere göre 3 kat daha yüksek olduğunu saptadı. Risk artışı bekar erkeklerde %68, bekar kadınlarda ise %85 daha yüksek düzeyindeydi.
Evlilik Kanserden Koruyor! 4 Milyon Hasta Verisi: Bekarlarda Kanser Riski 3 Kat Daha FazlaABD’de 4 milyondan fazla kanser vakasını inceleyen bilim insanları hiç evlenmemiş yetişkinlerde kanser riskinin evli veya boşanmış kişilere göre 3 kat daha yüksek olduğunu saptadı. Risk artışı bekar erkeklerde %68, bekar kadınlarda ise %85 daha yüksek düzeyindeydi.
Hüseyin Kandemir wrote a new post, Kanser ve Genetik Hastalıkların Tedavisinde Yeni Dönem: Nanopartiküller ile Gen Transferi 3 hafta 6 gün önce
 Kanser ve Genetik Hastalıkların Tedavisinde Yeni Dönem: Nanopartiküller ile Gen TransferiMichigan Üniversitesi araştırmacıları, viral vektör kullanmadan plazmid DNA ve mRNA’yı farklı insan hücre tiplerine taşıyabilen serum albümini bazlı nanopartiküller geliştirdi. Çalışmada, bu platform ile üretilen nanopartiküllerin hücreler tarafından %95 oranında absorbe edildi.
Kanser ve Genetik Hastalıkların Tedavisinde Yeni Dönem: Nanopartiküller ile Gen TransferiMichigan Üniversitesi araştırmacıları, viral vektör kullanmadan plazmid DNA ve mRNA’yı farklı insan hücre tiplerine taşıyabilen serum albümini bazlı nanopartiküller geliştirdi. Çalışmada, bu platform ile üretilen nanopartiküllerin hücreler tarafından %95 oranında absorbe edildi.
Hüseyin Kandemir wrote a new post, Yeni Nesil Nanoterapi İlaca Dirençli Kanser Hücrelerini Başarıyla Yok Etti! 1 ay önce
 Yeni Nesil Nanoterapi İlaca Dirençli Kanser Hücrelerini Başarıyla Yok Etti!Yeni geliştirilen ve ışıkla aktive olan bakır nanopartiküller, ilaca dirençli kanserlerde cuproptosis’i tetikleyerek tümör hücrelerini hiçbir yan etkiye yol açmadan başarıyla yok etti. Yeni tedavi mevcut kemoterapi ilaçlarından 100 kat daha güçlü bir etkiye sahip.
Yeni Nesil Nanoterapi İlaca Dirençli Kanser Hücrelerini Başarıyla Yok Etti!Yeni geliştirilen ve ışıkla aktive olan bakır nanopartiküller, ilaca dirençli kanserlerde cuproptosis’i tetikleyerek tümör hücrelerini hiçbir yan etkiye yol açmadan başarıyla yok etti. Yeni tedavi mevcut kemoterapi ilaçlarından 100 kat daha güçlü bir etkiye sahip.
Hüseyin Kandemir wrote a new post, Mayo Clinic’ten İleri Evre Kanserlere Karşı Nanopartikül Hipertermi Tedavisi! 1 ay 1 hafta önce
 Mayo Clinic’ten İleri Evre Kanserlere Karşı Nanopartikül Hipertermi Tedavisi!Mayo Clinic’te çalışmalarına yeni başlanan manyetik nanopartikül hipertermi tedavisi kansere karşı başarılı sonuçlar verdi. ABD’de tedaviye katılan ilk 30 hastada oldukça başarılı sonuçlar alınırken kayda değer bir yan etki saptanmadı.
Mayo Clinic’ten İleri Evre Kanserlere Karşı Nanopartikül Hipertermi Tedavisi!Mayo Clinic’te çalışmalarına yeni başlanan manyetik nanopartikül hipertermi tedavisi kansere karşı başarılı sonuçlar verdi. ABD’de tedaviye katılan ilk 30 hastada oldukça başarılı sonuçlar alınırken kayda değer bir yan etki saptanmadı.
Hüseyin Kandemir wrote a new post, Yeni RNA Tedavisi, Kalp Krizi Sonrası Doku Hasarını Azaltırken Kalp Fonksiyonunu Koruyor! 1 ay 1 hafta önce
 Yeni RNA Tedavisi, Kalp Krizi Sonrası Doku Hasarını Azaltırken Kalp Fonksiyonunu Koruyor!Science dergisinde yayımlanan yeni bir araştırma, kalp krizinden sonra tek doz olarak uygulanan saRNA tedavisinin kalp hasarını önleyebileceğini gösterdi. Kemik kaslarına enjekte edilen bu yeni tedavi uzun süreli koruyucu etki gösterirken kalp yetmezliği gelişmesini önledi.
Yeni RNA Tedavisi, Kalp Krizi Sonrası Doku Hasarını Azaltırken Kalp Fonksiyonunu Koruyor!Science dergisinde yayımlanan yeni bir araştırma, kalp krizinden sonra tek doz olarak uygulanan saRNA tedavisinin kalp hasarını önleyebileceğini gösterdi. Kemik kaslarına enjekte edilen bu yeni tedavi uzun süreli koruyucu etki gösterirken kalp yetmezliği gelişmesini önledi.
Hüseyin Kandemir wrote a new post, Tıp Tarihinde Bir İlk! Çin, Felç Tedavisinde Beyin-Bilgisayar İmplantını Onayladı 1 ay 1 hafta önce
 Tıp Tarihinde Bir İlk! Çin, Felç Tedavisinde Beyin-Bilgisayar İmplantını OnayladıFelç tedavisinde devrim niteliğinde bir gelişme olarak görülen implant edilebilir beyin-bilgisayar arayüzü (BCI) sistemi Çin Ulusal Tıbbi Ürünler İdaresi tarafından onaylandı. Felçli hastalarda el hareketlerini geri kazandıran cihaz bu alanda gerçek hasta kullanıma sunulan ilk implant oldu.
Tıp Tarihinde Bir İlk! Çin, Felç Tedavisinde Beyin-Bilgisayar İmplantını OnayladıFelç tedavisinde devrim niteliğinde bir gelişme olarak görülen implant edilebilir beyin-bilgisayar arayüzü (BCI) sistemi Çin Ulusal Tıbbi Ürünler İdaresi tarafından onaylandı. Felçli hastalarda el hareketlerini geri kazandıran cihaz bu alanda gerçek hasta kullanıma sunulan ilk implant oldu.
Hüseyin Kandemir wrote a new post, Alternatif Tıbbı Tercih Eden Kanser Hastalarında Ölüm Riski Dört Kat Artıyor! 1 ay 3 hafta önce
 Alternatif Tıbbı Tercih Eden Kanser Hastalarında Ölüm Riski Dört Kat Artıyor!ABD’de yürütülen kapsamlı bir araştırmanın sonuçlarına göre, kanıta dayalı tedaviler yerine alternatif tıbbı (ATT) tercih eden meme kanseri hastalarında ölüm riski ciddi şekilde artıyor. 2 milyon hastanın verilerini inceleyen çalışma, yalnızca ATT kullanan hastalarda ölüm riskinin dört kat arttığını gösterdi.
Alternatif Tıbbı Tercih Eden Kanser Hastalarında Ölüm Riski Dört Kat Artıyor!ABD’de yürütülen kapsamlı bir araştırmanın sonuçlarına göre, kanıta dayalı tedaviler yerine alternatif tıbbı (ATT) tercih eden meme kanseri hastalarında ölüm riski ciddi şekilde artıyor. 2 milyon hastanın verilerini inceleyen çalışma, yalnızca ATT kullanan hastalarda ölüm riskinin dört kat arttığını gösterdi.
Hüseyin Kandemir wrote a new post, Tümör ve Mikrobiyom İlişkisi: Yeni Keşif Kanser Tedavisinde Devrim Gibi Bir Değişime Neden Olabilir 2 ay önce
 Tümör ve Mikrobiyom İlişkisi: Yeni Keşif Kanser Tedavisinde Devrim Gibi Bir Değişime Neden OlabilirBağırsak bakterileri besinlerin tümörleri mi yoksa bağışıklık sistemini mi güçlendireceğine karar veriyor. Bağırsak mikrobiyotası ile ilgili yeni yapılan bir keşif, kanser tedavisindeki mevcut paradigmayı önemli oranda değiştirebilir. Araştırmanın odağında bağırsaklardaki Bacteroides ovatusyer yer alıyor.
Tümör ve Mikrobiyom İlişkisi: Yeni Keşif Kanser Tedavisinde Devrim Gibi Bir Değişime Neden OlabilirBağırsak bakterileri besinlerin tümörleri mi yoksa bağışıklık sistemini mi güçlendireceğine karar veriyor. Bağırsak mikrobiyotası ile ilgili yeni yapılan bir keşif, kanser tedavisindeki mevcut paradigmayı önemli oranda değiştirebilir. Araştırmanın odağında bağırsaklardaki Bacteroides ovatusyer yer alıyor.
Hüseyin Kandemir wrote a new post, Eski Epilepsi İlacı Alzheimer Tedavisinde Umut Olabilir: Plak Oluşumunu Başlamadan Durduruyor 2 ay 2 hafta önce
 Eski Epilepsi İlacı Alzheimer Tedavisinde Umut Olabilir: Plak Oluşumunu Başlamadan DurduruyorYeni yayımlanan bir çalışmaya göre halen kullanımda olan epilepsi ilacı levetirasetamın Alzheimer’da toksik amiloid-beta 42 üretimini engelleyerek hastalığı erken aşamalarda durdurabilir. Araştırmada, levetirasetam kullanan hastalarda bilişsel gerilemenin azaldığı saptandı.
Eski Epilepsi İlacı Alzheimer Tedavisinde Umut Olabilir: Plak Oluşumunu Başlamadan DurduruyorYeni yayımlanan bir çalışmaya göre halen kullanımda olan epilepsi ilacı levetirasetamın Alzheimer’da toksik amiloid-beta 42 üretimini engelleyerek hastalığı erken aşamalarda durdurabilir. Araştırmada, levetirasetam kullanan hastalarda bilişsel gerilemenin azaldığı saptandı.
Hüseyin Kandemir wrote a new post, 73 Randomize Çalışma: Egzersiz, Depresyon Tedavisinde Etkili Bir Seçenek Olabilir 3 ay 3 hafta önce
 73 Randomize Çalışma: Egzersiz, Depresyon Tedavisinde Etkili Bir Seçenek OlabilirLancashire Üniversitesi’nden araştırmacılar tarafından yapılan ve 73 randomize çalışmanın analizine dayanan bir Cochrane derlemesi egzersizin depresyon tedavisinde psikoterapi ve antidepresan ilaçlar kadar etkili olabildiğini gösterdi.
73 Randomize Çalışma: Egzersiz, Depresyon Tedavisinde Etkili Bir Seçenek OlabilirLancashire Üniversitesi’nden araştırmacılar tarafından yapılan ve 73 randomize çalışmanın analizine dayanan bir Cochrane derlemesi egzersizin depresyon tedavisinde psikoterapi ve antidepresan ilaçlar kadar etkili olabildiğini gösterdi.
Hüseyin Kandemir wrote a new post, Yapay Zeka, Pankreas Kanserini Radyologlardan Daha Doğru ve Hızlı Tespit Ediyor 3 ay 3 hafta önce
 Yapay Zeka, Pankreas Kanserini Radyologlardan Daha Doğru ve Hızlı Tespit EdiyorUluslararası PANORAMA çalışması, yapay zekanın rutin BT taramalarında pankreas kanserini radyologlardan çok daha doğru saptayabildiğini gösterdi. Toplam 3.440 hastayı kapsayan analizde yapay zeka, radyologların 0,88’lik performansına kıyasla 0,92 AUROC değerine ulaştı.
Yapay Zeka, Pankreas Kanserini Radyologlardan Daha Doğru ve Hızlı Tespit EdiyorUluslararası PANORAMA çalışması, yapay zekanın rutin BT taramalarında pankreas kanserini radyologlardan çok daha doğru saptayabildiğini gösterdi. Toplam 3.440 hastayı kapsayan analizde yapay zeka, radyologların 0,88’lik performansına kıyasla 0,92 AUROC değerine ulaştı.
Hüseyin Kandemir wrote a new post, Bağışıklık Sistemini Yeniden Programlayan Virüs Tedavisi Beyin Kanserinde Başarılı Oldu! 3 ay 4 hafta önce
 Bağışıklık Sistemini Yeniden Programlayan Virüs Tedavisi Beyin Kanserinde Başarılı Oldu!Bilim insanları beyin kanseri tümörlerini seçici olarak enfekte ederek yok edebilen ve beş farklı immünomodülatör taşıyan bir HSV-1 onkolitik virüs türü geliştirdi. Yeniden programlanabilen bu virüsler kanser hücrelerini yok ederken sağlıklı beyin dokusuna zarar vermiyor.
Bağışıklık Sistemini Yeniden Programlayan Virüs Tedavisi Beyin Kanserinde Başarılı Oldu!Bilim insanları beyin kanseri tümörlerini seçici olarak enfekte ederek yok edebilen ve beş farklı immünomodülatör taşıyan bir HSV-1 onkolitik virüs türü geliştirdi. Yeniden programlanabilen bu virüsler kanser hücrelerini yok ederken sağlıklı beyin dokusuna zarar vermiyor.
Hüseyin Kandemir wrote a new post, Kanal Tedavisi Diyabet ve Kalp Hastalığı Riskini Önemli Oranda Azaltıyor 4 ay 2 hafta önce
 Kanal Tedavisi Diyabet ve Kalp Hastalığı Riskini Önemli Oranda AzaltıyorAğız içindeki küçük bir enfeksiyonun tüm vücut metabolizmasını nasıl olumsuz etkileyebileceği bugüne kadar yeterince dikkate alınmamıştı. Yeni yapılan bir araştırmaya göre, apikal periodontitis gibi ağız enfeksiyonları, diyabet ve kalp hastalıkları riskini önemli oranda arttırıyor.
Kanal Tedavisi Diyabet ve Kalp Hastalığı Riskini Önemli Oranda AzaltıyorAğız içindeki küçük bir enfeksiyonun tüm vücut metabolizmasını nasıl olumsuz etkileyebileceği bugüne kadar yeterince dikkate alınmamıştı. Yeni yapılan bir araştırmaya göre, apikal periodontitis gibi ağız enfeksiyonları, diyabet ve kalp hastalıkları riskini önemli oranda arttırıyor.
Hüseyin Kandemir wrote a new post, Yapay Organ Üretiminde Eşik Aşıldı: İlaç Testleri ve Kanser Tedavisi İçin Devrimsel Bir Platform 4 ay 3 hafta önce
 Yapay Organ Üretiminde Eşik Aşıldı: İlaç Testleri ve Kanser Tedavisi İçin Devrimsel Bir PlatformAlman bilim insanları yapay organ (organoid) üretiminde çok önemli bir ilerleme sağladı. Çok miktarda insan organoidi üretebilen otomatik bir biyoreaktör sistemi geliştirildi. Uzmanlar bu gelişme ile birlikte özellikle kişiye özel kanser tedavilerinin geliştirilmesi konusunda devrim niteliğinde bir eşiğin aşıldığını belirtiyor.
Yapay Organ Üretiminde Eşik Aşıldı: İlaç Testleri ve Kanser Tedavisi İçin Devrimsel Bir PlatformAlman bilim insanları yapay organ (organoid) üretiminde çok önemli bir ilerleme sağladı. Çok miktarda insan organoidi üretebilen otomatik bir biyoreaktör sistemi geliştirildi. Uzmanlar bu gelişme ile birlikte özellikle kişiye özel kanser tedavilerinin geliştirilmesi konusunda devrim niteliğinde bir eşiğin aşıldığını belirtiyor.
Hüseyin Kandemir wrote a new post, Ölümcül Süper Mikroplara Karşı 100 Kat Daha Güçlü Yeni Bir Antibiyotik Keşfedildi 6 ay önce
Ölümcül Süper Mikroplara Karşı 100 Kat Daha Güçlü Yeni Bir Antibiyotik KeşfedildiBilim insanları, MRSA ve VRE gibi ölümcül süper mikroplara karşı mevcut ilaçlardan 100 kat daha güçlü yeni bir antibiyotik keşfetti. Streptomyces coelicolor bakterisinde bulunan pre-metilenomisin C lakton isimli bileşik, laboratuvar testlerinde oldukça başarılı sonuçlar sağladı.
Ölümcül Süper Mikroplara Karşı 100 Kat Daha Güçlü Yeni Bir Antibiyotik KeşfedildiBilim insanları, MRSA ve VRE gibi ölümcül süper mikroplara karşı mevcut ilaçlardan 100 kat daha güçlü yeni bir antibiyotik keşfetti. Streptomyces coelicolor bakterisinde bulunan pre-metilenomisin C lakton isimli bileşik, laboratuvar testlerinde oldukça başarılı sonuçlar sağladı.
Hüseyin Kandemir wrote a new post, Bilim İnsanları Nano-parçacık Tedavisiyle Alzheimer’ı Tersine Çevirmeyi Başardı 6 ay önce
 Bilim İnsanları Nano-parçacık Tedavisiyle Alzheimer’ı Tersine Çevirmeyi BaşardıBilim insanları, sadece 3 nanopartikül enjeksiyonuyla Alzheimer hastalığını tersine çevirmeyi başardı. Kan-beyin bariyerini onaran bu yeni tedavi yönteminde hastalığın etkilerini hedefleyen nanoparçacıklar, sadece bir saat içinde beyindeki amiloid-beta düzeyini %50–60 azalttı
Bilim İnsanları Nano-parçacık Tedavisiyle Alzheimer’ı Tersine Çevirmeyi BaşardıBilim insanları, sadece 3 nanopartikül enjeksiyonuyla Alzheimer hastalığını tersine çevirmeyi başardı. Kan-beyin bariyerini onaran bu yeni tedavi yönteminde hastalığın etkilerini hedefleyen nanoparçacıklar, sadece bir saat içinde beyindeki amiloid-beta düzeyini %50–60 azalttı
Hüseyin Kandemir wrote a new post, Kanser Tedavisindeki Kayıp Halka Bulundu: Timus Sağlığı Ölüm Riskini %44 Azaltıyor 6 ay 2 hafta önce
 Kanser Tedavisindeki Kayıp Halka Bulundu: Timus Sağlığı Ölüm Riskini %44 AzaltıyorYapay zeka ile kanser hastalarının tomografi sonuçlarını analiz eden bilim insanları kanser tedavisinde ‘Kayıp Halka’ denebilecek çok önemli bir keşif yaptılar. ESMO 2025’te sunulan çalışmaya göre, timus sağlığı analizi, pek çok kanser türünde immünoterapinin başarısını öngörebiliyor ve ölüm riskini %44 azaltıyor
Kanser Tedavisindeki Kayıp Halka Bulundu: Timus Sağlığı Ölüm Riskini %44 AzaltıyorYapay zeka ile kanser hastalarının tomografi sonuçlarını analiz eden bilim insanları kanser tedavisinde ‘Kayıp Halka’ denebilecek çok önemli bir keşif yaptılar. ESMO 2025’te sunulan çalışmaya göre, timus sağlığı analizi, pek çok kanser türünde immünoterapinin başarısını öngörebiliyor ve ölüm riskini %44 azaltıyor
Hüseyin Kandemir wrote a new post, Kanser Karşı Truva Atı: Peptid Nanotüpler, İlaç Dirençli Tümörleri Bile Yok Edebiliyor 6 ay 2 hafta önce
 Kanser Karşı Truva Atı: Peptid Nanotüpler, İlaç Dirençli Tümörleri Bile Yok EdebiliyorACS Applied dergisinde yayımlanan bir çalışmanın sonuçlarına göre, yeni geliştirilen peptid nanotüpler ile dirençli tümör hücrelerini bile yok etmek mümkün olabilecek. Moleküler düzeyde tasarlanan bu nanotüplerin içine gizlenen ilaçlar doğrudan kanserli hücreleri yok ediyor.
Kanser Karşı Truva Atı: Peptid Nanotüpler, İlaç Dirençli Tümörleri Bile Yok EdebiliyorACS Applied dergisinde yayımlanan bir çalışmanın sonuçlarına göre, yeni geliştirilen peptid nanotüpler ile dirençli tümör hücrelerini bile yok etmek mümkün olabilecek. Moleküler düzeyde tasarlanan bu nanotüplerin içine gizlenen ilaçlar doğrudan kanserli hücreleri yok ediyor.